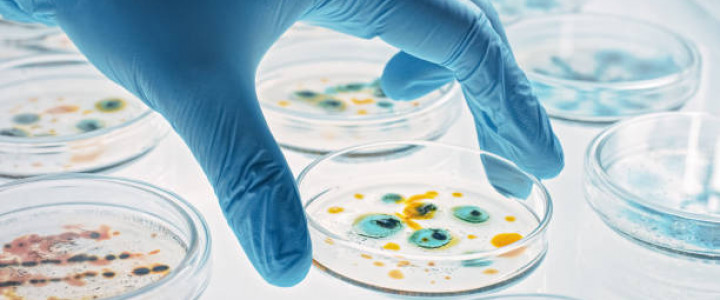
imagine TEHNICIAN CHIMIST DE LABORATOR

-copie buletin / carte de identitate.
-copie certificat de naştere.
-copie certificat de căsătorie / divorț (în cazul doamnelor).
-copie act de studiu
-adeverinta medicala.
Curs: Tehnician Chimist de Laborator
- Data începerii
- La formarea grupei
- Durata
- 1080 ore
- Perioada înscrierii
- Până la formarea grupei
- Organizator
- ACCRC INTERNATIONAL
- Ultima actualizare
- 1 August 2024
Competenţe dobândite
1. Pregatirea materiilor prime si a materialelor auxiliare din industria chimică
2. Exploatarea utilajelor mecanice si hidraulice din industria chimică
3. Efectuarea analizelor materiilor prime, a materialelor auxiliare si a produselor din industria chimică
4. Exploatarea utilajelor de transfer termic si de masă din industria chimică
5. Planificarea si organizarea productiei
6. Aplicarea procedurilor de calitate in activitati specifice industriei chimice.
7.Organizarea si gestionarea activitatii laboratorului aplicand procedee si norme specifice
8.Realizarea de analize prin metode chimice , evaluarea si raportarea rezultatelor
9. Aplicarea tehnicilor instrumentale in analize chimice, evaluarea si raportarea rezultatelor
10. Determinarea caracteristicilor de calitate a produselor chimice
ACCRC INTERNATIONAL

Atenție: acest curs nu este organizat de e-calificare.ro. Pentru detalii și informații suplimentare vă rugăm să vă adresați organizatorului. Acuratețea informațiilor din anunț este responsabilitatea integrală a companiei care a publicat anunțul.